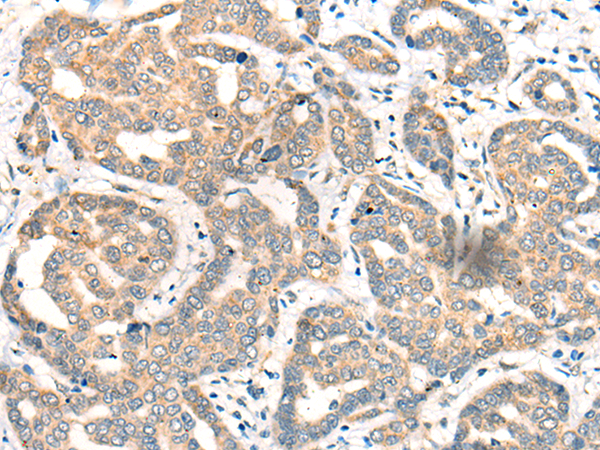

中文名稱(chēng):兔抗CDK2AP1多克隆抗體
英文名稱(chēng): Anti-CDK2AP1 rabbit polyclonal antibody
別 名: cyclin dependent kinase 2 associated protein 1; DOC1; ST19; DORC1; doc-1; p12DOC-1
儲(chǔ) 存: 冷凍(-20℃)
宿 主: Rabbit
抗 原: CDK2AP1
反應(yīng)種屬: Human, Mouse
標(biāo) 記 物: Unconjugate
克隆類(lèi)型: rabbit polyclonal
技術(shù)規(guī)格
|
Background: |
The protein encoded by this gene is a cyclin-dependent kinase 2 (CDK2) -associated protein which is thought to negatively regulate CDK2 activity by sequestering monomeric CDK2, and targeting CDK2 for proteolysis. This protein was found to also interact with DNA polymerase alpha/primase and mediate the phosphorylation of the large p180 subunit, which suggests a regulatory role in DNA replication during the S-phase of the cell cycle. This protein also forms a core subunit of the nucleosome remodeling and histone deacetylation (NURD) complex that epigenetically regulates embryonic stem cell differentiation. This gene thus plays a role in both cell-cycle and epigenetic regulation. Alternative splicing results in multiple transcript variants encoding distinct isoforms. |
|
Applications: |
ELISA, IHC |
|
Name of antibody: |
CDK2AP1 |
|
Immunogen: |
Full length fusion protein |
|
Full name: |
cyclin dependent kinase 2 associated protein 1 |
|
Synonyms: |
DOC1; ST19; DORC1; doc-1; p12DOC-1 |
|
SwissProt: |
O14519 |
|
ELISA Recommended dilution: |
5000-10000 |
|
IHC positive control: |
Human liver cancer |
|
IHC Recommend dilution: |
25-100 |
購(gòu)物車(chē)
購(gòu)物車(chē) 幫助
幫助
 021-54845833/15800441009
021-54845833/15800441009
